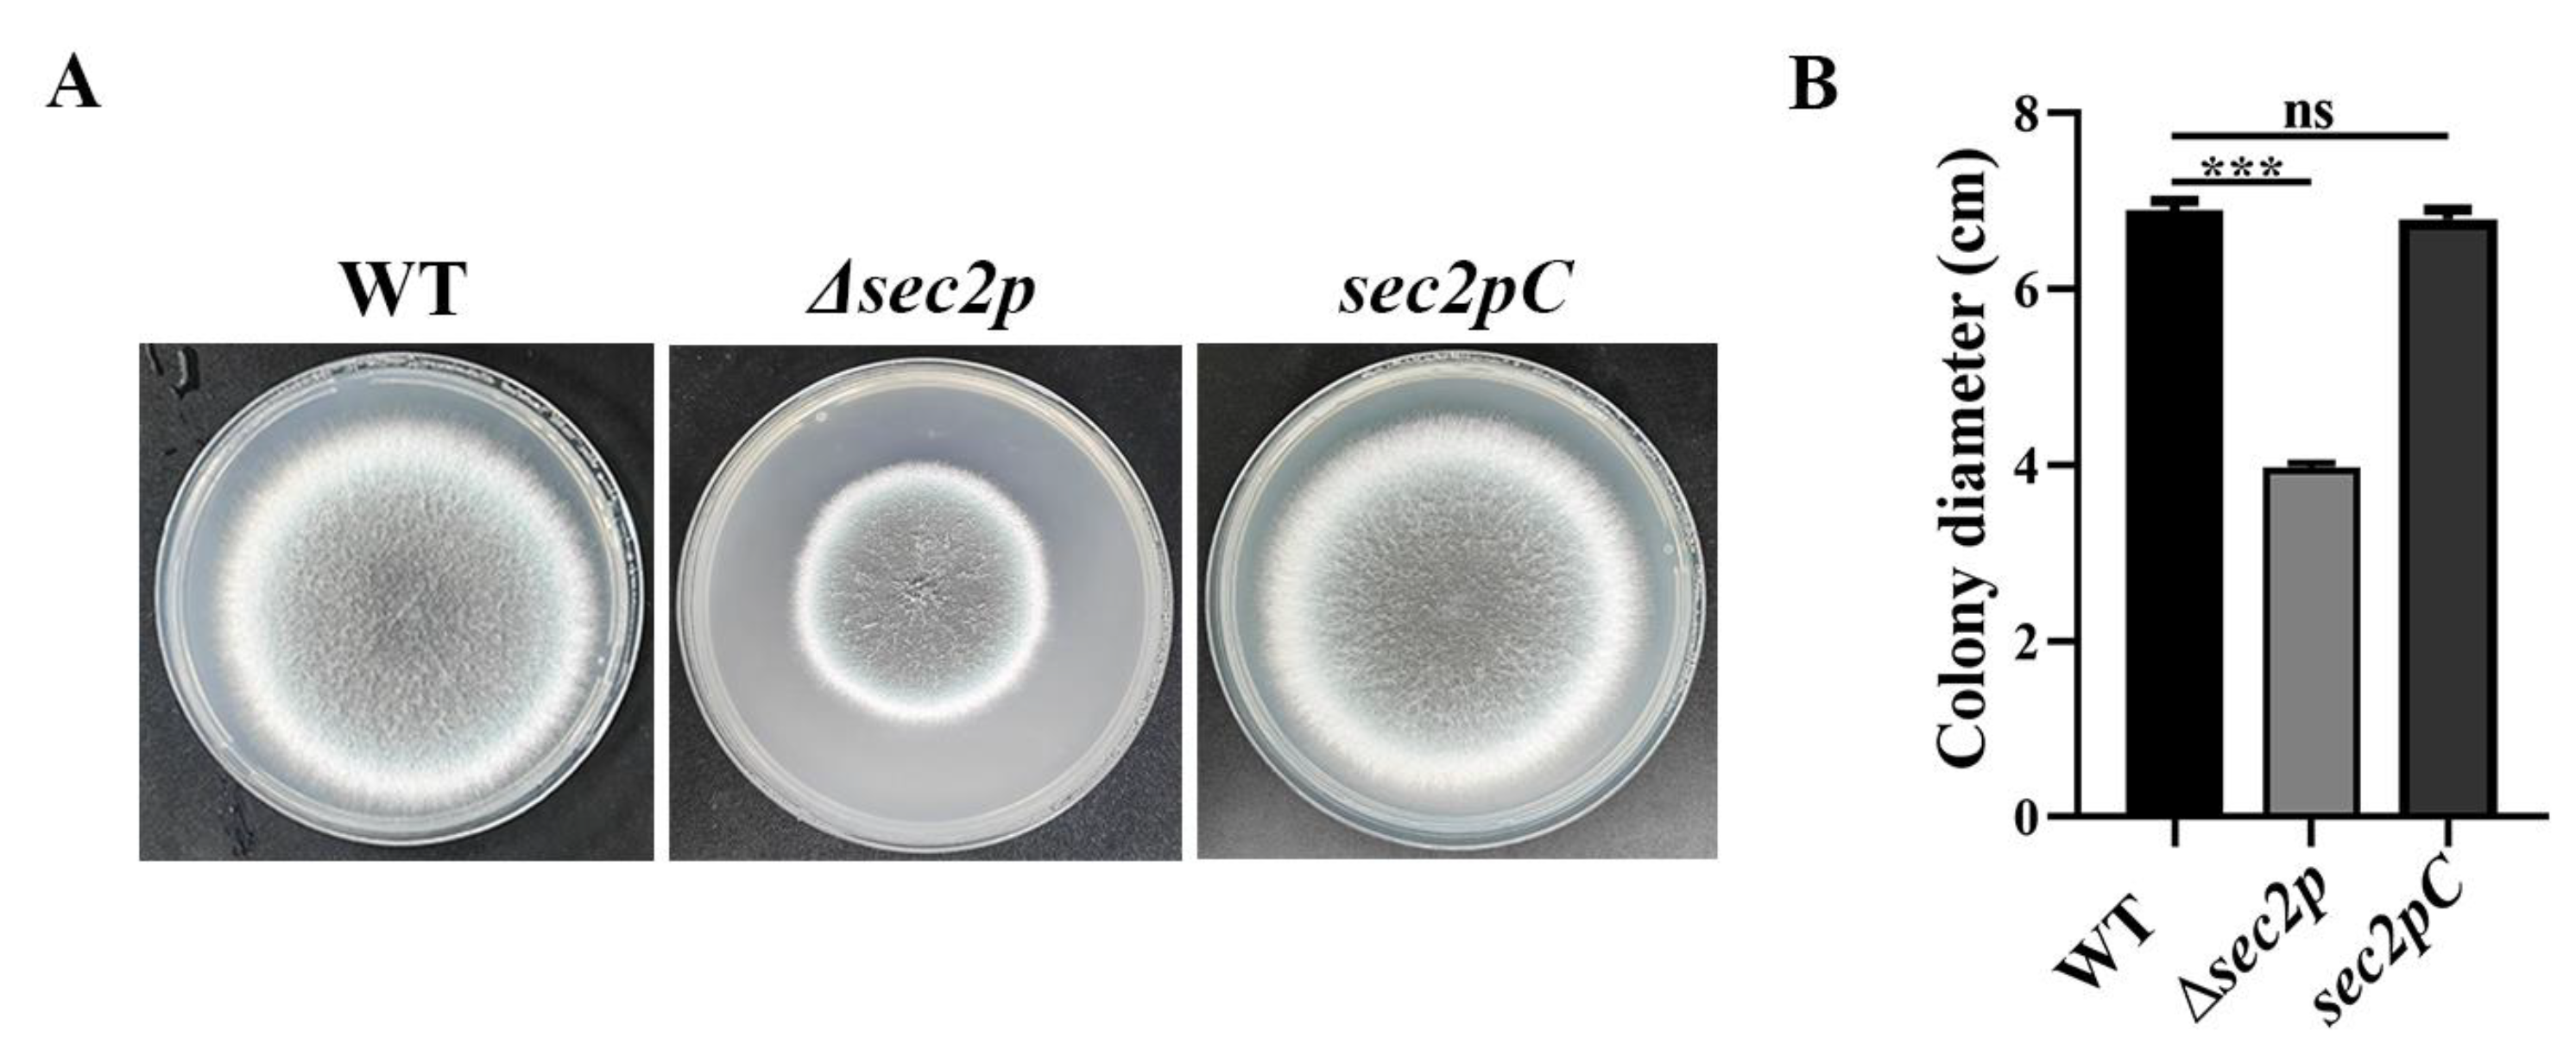
Jof 11 00036 g001 Jof 11 00036 g001

Roles of the Sec2p Gene in the Growth and Pathogenicity Regulation of Aspergillus fumigatus
Abstract
1. Introduction
2. Materials and Methods
2.1. Bacterial Strains, Cells, and Plasmids
2.2. Construction of the Sec2p Deletion and Complementation Strains
2.3. Morphological Examination
2.4. Animal Infection Models
2.5. Fungal Burden and Histopathology Assays
2.6. MDC Staining
2.7. Quantitative Real-Time PCR (qRT-PCR) Analysis
2.8. Data Analysis
3. Results
3.1. Generation and Gene Analysis of the Sec2p Mutant Strain
3.2. Phenotypic Analysis of the Sec2p Mutant
3.3. Sec2p Deletion Reduces the Virulence of A. fumigatus
3.4. Sec2p Deletion Affects the Autophagy Pathway in A. fumigatus
3.5. Sec2p Regulates the CWI Pathway to Participate in the Stress Response of A. fumigatus Cells
3.6. The Effect of Sec2p on the Autophagy Pathway and CWI Pathway-Related Gene Expression Levels in A. fumigatus
3.6.1. Autophagy-Related Gene Expression
3.6.2. The Expression of CWI Pathway Genes
3.6.3. Under Rapamycin Induction, Sec2p Positively Regulates the Autophagy Pathway to Enhance the Expression of Genes in the CWI Pathway
4. Discussion
Supplementary Materials
Author Contributions
Funding
Institutional Review Board Statement
Informed Consent Statement
Data Availability Statement
Acknowledgments
Conflicts of Interest
References
- Brown, G.D.; Denning, D.W.; Gow, N.A.R.; Levitz, S.M.; Netea, M.G.; White, T.C. Hidden Killers: Human Fungal Infections. Sci. Transl. Med. 2012, 4, 165rv13. [Google Scholar] [CrossRef]
- Seagle, E.E.; Williams, S.L.; Chiller, T.M. Recent Trends in the Epidemiology of Fungal Infections. Infect. Dis. Clin. N. Am. 2021, 35, 237–260. [Google Scholar] [CrossRef] [PubMed]
- Steinbrink, J.M.; Hong, D.K.; Bergin, S.P.; Al-Rohil, R.N.; Perfect, J.R.; Maziarz, E.K. The Robust and Rapid Role of Molecular Testing in Precision Fungal Diagnostics: A Case Report. Med. Mycol. Case Rep. 2020, 27, 77–80. [Google Scholar] [CrossRef]
- White, P.L.; Alanio, A.; Brown, L.; Cruciani, M.; Hagen, F.; Gorton, R.; Lackner, M.; Millon, L.; Morton, C.O.; Rautemaa-Richardson, R.; et al. An Overview of Using Fungal DNA for the Diagnosis of Invasive Mycoses. Expert Rev. Mol. Diagn. 2022, 22, 169–184. [Google Scholar] [CrossRef]
- Abad, A.; Fernández-Molina, J.V.; Bikandi, J.; Ramírez, A.; Margareto, J.; Sendino, J.; Hernando, F.L.; Pontón, J.; Garaizar, J.; Rementeria, A. What Makes Aspergillus fumigatus a Successful Pathogen? Genes and Molecules Involved in Invasive Aspergillosis. Rev. Iberoam. Micol. 2010, 27, 155–182. [Google Scholar] [CrossRef]
- Walch-Solimena, C.; Collins, R.N.; Novick, P.J. Sec2p Mediates Nucleotide Exchange on Sec4p and Is Involved in Polarized Delivery of Post-Golgi Vesicles. J. Cell Biol. 1997, 137, 1495–1509. [Google Scholar] [CrossRef]
- Itzen, A.; Rak, A.; Goody, R.S. Sec2 Is a Highly Efficient Exchange Factor for the Rab Protein Sec4. J. Mol. Biol. 2007, 365, 1359–1367. [Google Scholar] [CrossRef] [PubMed]
- Rinaldi, F.C.; Packer, M.; Collins, R. New Insights into the Molecular Mechanism of the Rab GTPase Sec4p Activation. BMC Struct. Biol. 2015, 15, 14. [Google Scholar] [CrossRef]
- Geng, J.; Nair, U.; Yasumura-Yorimitsu, K.; Klionsky, D.J. Post-Golgi Sec Proteins Are Required for Autophagy in Saccharomyces cerevisiae. Mol. Biol. Cell 2010, 21, 2257–2269. [Google Scholar] [CrossRef] [PubMed]
- Nair, J.; Müller, H.; Peterson, M.; Novick, P. Sec2 Protein Contains a Coiled-Coil Domain Essential for Vesicular Transport and a Dispensable Carboxy Terminal Domain. J. Cell Biol. 1990, 110, 1897–1909. [Google Scholar] [CrossRef]
- Kwon, M.J.; Arentshorst, M.; Fiedler, M.; de Groen, F.L.M.; Punt, P.J.; Meyer, V.; Ram, A.F.J. Molecular Genetic Analysis of Vesicular Transport in Aspergillus niger Reveals Partial Conservation of the Molecular Mechanism of Exocytosis in Fungi. Microbiology 2014, 160, 316–329. [Google Scholar] [CrossRef]
- Bishop, A.; Lane, R.; Beniston, R.; Chapa-y-Lazo, B.; Smythe, C.; Sudbery, P. Hyphal Growth in Candida albicans Requires the Phosphorylation of Sec2 by the Cdc28-Ccn1/Hgc1 Kinase. EMBO J. 2010, 29, 2930–2942. [Google Scholar] [CrossRef] [PubMed]
- Liu, X.-H.; Lu, J.-P.; Lin, F.-C. Autophagy during Conidiation, Conidial Germination and Turgor Generation in Magnaporthe grisea. Autophagy 2007, 3, 472–473. [Google Scholar] [CrossRef]
- Zhu, X.-M.; Li, L.; Wu, M.; Liang, S.; Shi, H.-B.; Liu, X.-H.; Lin, F.-C. Current Opinions on Autophagy in Pathogenicity of Fungi. Virulence 2019, 10, 481–489. [Google Scholar] [CrossRef] [PubMed]
- Ravanan, P.; Srikumar, I.F.; Talwar, P. Autophagy: The Spotlight for Cellular Stress Responses. Life Sci. 2017, 188, 53–67. [Google Scholar] [CrossRef] [PubMed]
- Mizushima, N.; Komatsu, M. Autophagy: Renovation of Cells and Tissues. Cell 2011, 147, 728–741. [Google Scholar] [CrossRef]
- Parzych, K.R.; Klionsky, D.J. An Overview of Autophagy: Morphology, Mechanism, and Regulation. Antioxid. Redox Signal 2014, 20, 460–473. [Google Scholar] [CrossRef] [PubMed]
- Liu, X.-H.; Xu, F.; Snyder, J.H.; Shi, H.-B.; Lu, J.-P.; Lin, F.-C. Autophagy in Plant Pathogenic Fungi. Semin. Cell Dev. Biol. 2016, 57, 128–137. [Google Scholar] [CrossRef] [PubMed]
- Corral-Ramos, C.; Roca, M.G.; Di Pietro, A.; Roncero, M.I.G.; Ruiz-Roldán, C. Autophagy Contributes to Regulation of Nuclear Dynamics during Vegetative Growth and Hyphal Fusion in Fusarium oxysporum. Autophagy 2015, 11, 131–144. [Google Scholar] [CrossRef] [PubMed]
- Guo, P.; Wang, Y.; Xu, J.; Yang, Z.; Zhang, Z.; Qian, J.; Hu, J.; Yin, Z.; Yang, L.; Liu, M.; et al. Autophagy and Cell Wall Integrity Pathways Coordinately Regulate the Development and Pathogenicity through MoAtg4 Phosphorylation in Magnaporthe oryzae. PLoS Pathog. 2024, 20, e1011988. [Google Scholar] [CrossRef] [PubMed]
- Xie, Z.; Nair, U.; Klionsky, D.J. Atg8 Controls Phagophore Expansion during Autophagosome Formation. Mol. Biol. Cell 2008, 19, 3290–3298. [Google Scholar] [CrossRef]
- Josefsen, L.; Droce, A.; Sondergaard, T.E.; Sørensen, J.L.; Bormann, J.; Schäfer, W.; Giese, H.; Olsson, S. Autophagy Provides Nutrients for Nonassimilating Fungal Structures and Is Necessary for Plant Colonization but Not for Infection in the Necrotrophic Plant Pathogen Fusarium Graminearum. Autophagy 2012, 8, 326–337. [Google Scholar] [CrossRef]
- Kikuma, T.; Ohneda, M.; Arioka, M.; Kitamoto, K. Functional Analysis of the ATG8 Homologue Aoatg8 and Role of Autophagy in Differentiation and Germination in Aspergillus oryzae. Eukaryot. Cell 2006, 5, 1328–1336. [Google Scholar] [CrossRef]
- Licheva, M.; Raman, B.; Kraft, C.; Reggiori, F. Phosphoregulation of the Autophagy Machinery by Kinases and Phosphatases. Autophagy 2022, 18, 104–123. [Google Scholar] [CrossRef]
- Fan, Z.; Yu, H.; Guo, Q.; He, D.; Xue, B.; Xie, X.; Yokoyama, K.; Wang, L. Identification and Characterization of an Anti-Oxidative Stress-Associated Mutant of Aspergillus fumigatus Transformed by Agrobacterium tumefaciens. Mol. Med. Rep. 2016, 13, 2367. [Google Scholar] [CrossRef][Green Version]
- Gao, S.; He, D.; Li, G.; Zhang, Y.; Lv, H.; Wang, L. A Method for Amplification of Unknown Flanking Sequences Based on Touchdown PCR and Suppression-PCR. Anal. Biochem. 2016, 509, 79–81. [Google Scholar] [CrossRef]
- Kubodera, T.; Yamashita, N.; Nishimura, A. Pyrithiamine Resistance Gene (ptrA) of Aspergillus oryzae: Cloning, Characterization and Application as a Dominant Selectable Marker for Transformation. Biosci. Biotechnol. Biochem. 2000, 64, 1416–1421. [Google Scholar] [CrossRef] [PubMed]
- Song, H.-Y.; Choi, D.; Han, D.-M.; Kim, D.-H.; Kim, J.-M. A Novel Rapid Fungal Promoter Analysis System Using the Phosphopantetheinyl Transferase Gene, npgA, in Aspergillus nidulans. Mycobiology 2018, 46, 429. [Google Scholar] [CrossRef]
- Weichert, M.; Guirao-Abad, J.; Aimanianda, V.; Krishnan, K.; Grisham, C.; Snyder, P.; Sheehan, A.; Abbu, R.R.; Liu, H.; Filler, S.G.; et al. Functional Coupling between the Unfolded Protein Response and Endoplasmic Reticulum/Golgi Ca2+-ATPases Promotes Stress Tolerance, Cell Wall Biosynthesis, and Virulence of Aspergillus fumigatus. mBio 2020, 11, e01060. [Google Scholar] [CrossRef]
- Sampathkumar, A.; Gutierrez, R.; McFarlane, H.E.; Bringmann, M.; Lindeboom, J.; Emons, A.-M.; Samuels, L.; Ketelaar, T.; Ehrhardt, D.W.; Persson, S. Patterning and Lifetime of Plasma Membrane-Localized Cellulose Synthase Is Dependent on Actin Organization in Arabidopsis Interphase Cells. Plant Physiol. 2013, 162, 675. [Google Scholar] [CrossRef] [PubMed]
- Zhou, H.; Hu, H.; Zhang, L.; Li, R.; Ouyang, H.; Ming, J.; Jin, C. O-Mannosyltransferase 1 in Aspergillus fumigatus (AfPmt1p) Is Crucial for Cell Wall Integrity and Conidium Morphology, Especially at an Elevated Temperature. Eukaryot. Cell 2007, 6, 2260. [Google Scholar] [CrossRef]
- Feng, C.; Zhang, M.; Zhang, S.; Zhang, J.; Li, C.; Zhou, J. Therapeutic Effects of Pentoxifylline on Invasive Pulmonary Aspergillosis in Immunosuppressed Mice. BMC Pulm. Med. 2021, 21, 31. [Google Scholar] [CrossRef]
- Diaz-Arevalo, D.; Bagramyan, K.; Hong, T.B.; Ito, J.I.; Kalkum, M. CD4+ T Cells Mediate the Protective Effect of the Recombinant Asp F3-Based Anti-Aspergillosis Vaccine. Infect. Immun. 2011, 79, 2257. [Google Scholar] [CrossRef]
- Chen, L.; Zhang, X.; Wang, W.; Geng, X.; Shi, Y.; Na, R.; Dou, D.; Li, H. Network and Role Analysis of Autophagy in Phytophthora sojae. Sci. Rep. 2017, 7, 1879. [Google Scholar] [CrossRef] [PubMed]
- Contento, A.L.; Xiong, Y.; Bassham, D.C. Visualization of Autophagy in Arabidopsis Using the Fluorescent Dye Monodansylcadaverine and a GFP-AtATG8e Fusion Protein. Plant J. 2005, 42, 598–608. [Google Scholar] [CrossRef] [PubMed]
- Chen, A.; Liu, N.; Xu, C.; Wu, S.; Liu, C.; Qi, H.; Ren, Y.; Han, X.; Yang, K.; Liu, X.; et al. The STRIPAK Complex Orchestrates Cell Wall Integrity Signalling to Govern the Fungal Development and Virulence of Fusarium graminearum. Mol. Plant Pathol. 2023, 24, 1139–1153. [Google Scholar] [CrossRef] [PubMed]
- Jiao, W.; Ding, W.; Rollins, J.A.; Liu, J.; Zhang, Y.; Zhang, X.; Pan, H. Cross-Talk and Multiple Control of Target of Rapamycin (TOR) in Sclerotinia Sclerotiorum. Microbiol. Spectr. 2023, 11, e00013-23. [Google Scholar] [CrossRef] [PubMed]
- Yin, Z.; Feng, W.; Chen, C.; Xu, J.; Li, Y.; Yang, L.; Wang, J.; Liu, X.; Wang, W.; Gao, C.; et al. Shedding Light on Autophagy Coordinating with Cell Wall Integrity Signaling to Govern Pathogenicity of Magnaporthe oryzae. Autophagy 2020, 16, 900–916. [Google Scholar] [CrossRef]
- Kong, Y.; Guo, P.; Xu, J.; Li, J.; Wu, M.; Zhang, Z.; Wang, Y.; Liu, X.; Yang, L.; Liu, M.; et al. MoMkk1 and MoAtg1 Dichotomously Regulating Autophagy and Pathogenicity through MoAtg9 Phosphorylation in Magnaporthe oryzae. mBio 2024, 15, e03344-23. [Google Scholar] [CrossRef]
- Reddy, P.V.; Puri, R.V.; Chauhan, P.; Kar, R.; Rohilla, A.; Khera, A.; Tyagi, A.K. Disruption of Mycobactin Biosynthesis Leads to Attenuation of Mycobacterium tuberculosis for Growth and Virulence. J. Infect. Dis. 2013, 208, 1255–1265. [Google Scholar] [CrossRef]
- Levine, B.; Kroemer, G. Biological Functions of Autophagy Genes: A Disease Perspective. Cell 2019, 176, 11. [Google Scholar] [CrossRef]
- Bartoszewska, M.; Kiel, J.A.K.W. The Role of Macroautophagy in Development of Filamentous Fungi. Antioxid. Redox Signal 2011, 14, 2271–2287. [Google Scholar] [CrossRef] [PubMed]
- Richie, D.L.; Fuller, K.K.; Fortwendel, J.; Miley, M.D.; McCarthy, J.W.; Feldmesser, M.; Rhodes, J.C.; Askew, D.S. Unexpected Link between Metal Ion Deficiency and Autophagy in Aspergillus fumigatus. Eukaryot. Cell 2007, 6, 2437. [Google Scholar] [CrossRef]
- Shoji, J.-Y.; Arioka, M.; Kitamoto, K. Possible Involvement of Pleiomorphic Vacuolar Networks in Nutrient Recycling in Filamentous Fungi. Autophagy 2006, 2, 226–227. [Google Scholar] [CrossRef] [PubMed]
- Hu, G.; Hacham, M.; Waterman, S.R.; Panepinto, J.; Shin, S.; Liu, X.; Gibbons, J.; Valyi-Nagy, T.; Obara, K.; Jaffe, H.A.; et al. PI3K Signaling of Autophagy Is Required for Starvation Tolerance and Virulenceof Cryptococcus neoformans. J. Clin. Investig. 2008, 118, 1186. [Google Scholar] [CrossRef]
- Zheng, Y.; Guo, P.; Deng, H.; Lin, Y.; Huang, G.; Wu, J.; Lu, S.; Yang, S.; Zhou, J.; Zheng, W.; et al. Small GTPase FoSec4-Mediated Protein Secretion Is Important for Polarized Growth, Reproduction and Pathogenicity in the Banana Fusarium Wilt Fungus Fusarium odoratissimum. J. Fungi 2022, 8, 880. [Google Scholar] [CrossRef]
- Ortiz, D.; Medkova, M.; Walch-Solimena, C.; Novick, P. Ypt32 Recruits the Sec4p Guanine Nucleotide Exchange Factor, Sec2p, to Secretory Vesicles; Evidence for a Rab Cascade in Yeast. J. Cell Biol. 2002, 157, 1005–1015. [Google Scholar] [CrossRef] [PubMed]
- Latgé, J.-P. Tasting the Fungal Cell Wall. Cell Microbiol. 2010, 12, 863–872. [Google Scholar] [CrossRef] [PubMed]
- Latgé, J.-P.; Beauvais, A.; Chamilos, G. The Cell Wall of the Human Fungal Pathogen Aspergillus fumigatus: Biosynthesis, Organization, Immune Response, and Virulence. Annu. Rev. Microbiol. 2017, 71, 99–116. [Google Scholar] [CrossRef] [PubMed]
- Levin, D.E. Regulation of Cell Wall Biogenesis in Saccharomyces cerevisiae: The Cell Wall Integrity Signaling Pathway. Genetics 2011, 189, 1145. [Google Scholar] [CrossRef]
- Cai, Y.; Liu, X.; Shen, L.; Wang, N.; He, Y.; Zhang, H.; Wang, P.; Zhang, Z. Homeostasis of Cell Wall Integrity Pathway Phosphorylation Is Required for the Growth and Pathogenicity of Magnaporthe oryzae. Mol. Plant Pathol. 2022, 23, 1214–1225. [Google Scholar] [CrossRef]
- Mao, K.; Wang, K.; Zhao, M.; Xu, T.; Klionsky, D.J. Two MAPK-Signaling Pathways Are Required for Mitophagy in Saccharomyces cerevisiae. J. Cell Biol. 2011, 193, 755. [Google Scholar] [CrossRef]
- Mao, K.; Klionsky, D.J. MAPKs Regulate Mitophagy in Saccharomyces cerevisiae. Autophagy 2011, 7, 1564. [Google Scholar] [CrossRef] [PubMed]
- Manjithaya, R.; Jain, S.; Farré, J.-C.; Subramani, S. A Yeast MAPK Cascade Regulates Pexophagy but Not Other Autophagy Pathways. J. Cell Biol. 2010, 189, 303. [Google Scholar] [CrossRef] [PubMed]

Disclaimer/Publisher’s Note: The statements, opinions and data contained in all publications are solely those of the individual author(s) and contributor(s) and not of MDPI and/or the editor(s). MDPI and/or the editor(s) disclaim responsibility for any injury to people or property resulting from any ideas, methods, instructions or products referred to in the content. |
© 2025 by the authors. Licensee MDPI, Basel, Switzerland. This article is an open access article distributed under the terms and conditions of the Creative Commons Attribution (CC BY) license (https://creativecommons.org/licenses/by/4.0/).
Share and Cite
Liu, Y.; Shang, S.; Liu, C.; Liu, Y.; Xu, K.; He, D.; Wang, L. Roles of the Sec2p Gene in the Growth and Pathogenicity Regulation of Aspergillus fumigatus. J. Fungi 2025, 11, 36. https://doi.org/10.3390/jof11010036
Liu Y, Shang S, Liu C, Liu Y, Xu K, He D, Wang L. Roles of the Sec2p Gene in the Growth and Pathogenicity Regulation of Aspergillus fumigatus. Journal of Fungi. 2025; 11(1):36. https://doi.org/10.3390/jof11010036
Chicago/Turabian StyleLiu, Yuhuan, Shumi Shang, Cong Liu, Yichen Liu, Keyang Xu, Dan He, and Li Wang. 2025. "Roles of the Sec2p Gene in the Growth and Pathogenicity Regulation of Aspergillus fumigatus" Journal of Fungi 11, no. 1: 36. https://doi.org/10.3390/jof11010036
APA StyleLiu, Y., Shang, S., Liu, C., Liu, Y., Xu, K., He, D., & Wang, L. (2025). Roles of the Sec2p Gene in the Growth and Pathogenicity Regulation of Aspergillus fumigatus. Journal of Fungi, 11(1), 36. https://doi.org/10.3390/jof11010036

